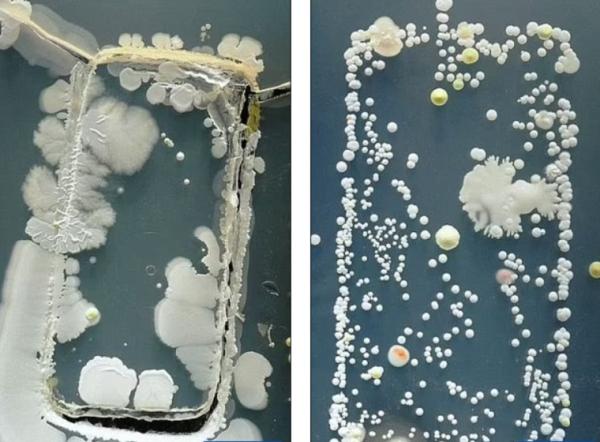
تحذير: استخدام الهاتف في السرير قد يؤدي إلى تعرضك للبكتيريا الضارة

أخبارنا المغربية - وكالات
حذرت دراسة جديدة من أن استخدام الهواتف الذكية في السرير قد يؤدي إلى مخاطر صحية تتجاوز تأثيره السلبي على النوم. وأشارت الدراسة إلى أن الهواتف قد تؤوي بكتيريا ضارة توجد عادة في فضلات الصراصير، والتي يمكن أن تسبب التهابات جلدية خطيرة، وحتى أمراضاً مثل الالتهاب الرئوي وتعفن الدم لدى الأفراد المعرضين للخطر.
وأظهرت الدراسة التي نُشرت في "دايلي ميل" أن الهواتف الذكية قد تحتوي على بكتيريا أكثر بعشر مرات من تلك الموجودة على مقاعد المراحيض. بعد اختبار عينات من عشرة هواتف ذكية، وجد الباحثون بكتيريا مثل Pseudomonas aeruginosa، وهي بكتيريا خطرة يمكن أن تعيش في البيئات الدافئة والرطبة، مثل تلك الموجودة في السرير.
وأشارت الدراسة إلى أن التلامس مع هذه الجراثيم قد يؤدي إلى إصابة الأشخاص بأمراض جلدية أو مشاكل صحية أخرى، خاصة لأولئك الذين ينامون وأجهزتهم بجانبهم أو تحت وسائدهم.
وللتخفيف من هذه المخاطر، أوصى الباحثون بتنظيف الهواتف بانتظام وتجنب استخدامها في السرير، حفاظاً على الصحة العامة ومنع التعرض للبكتيريا الضارة.